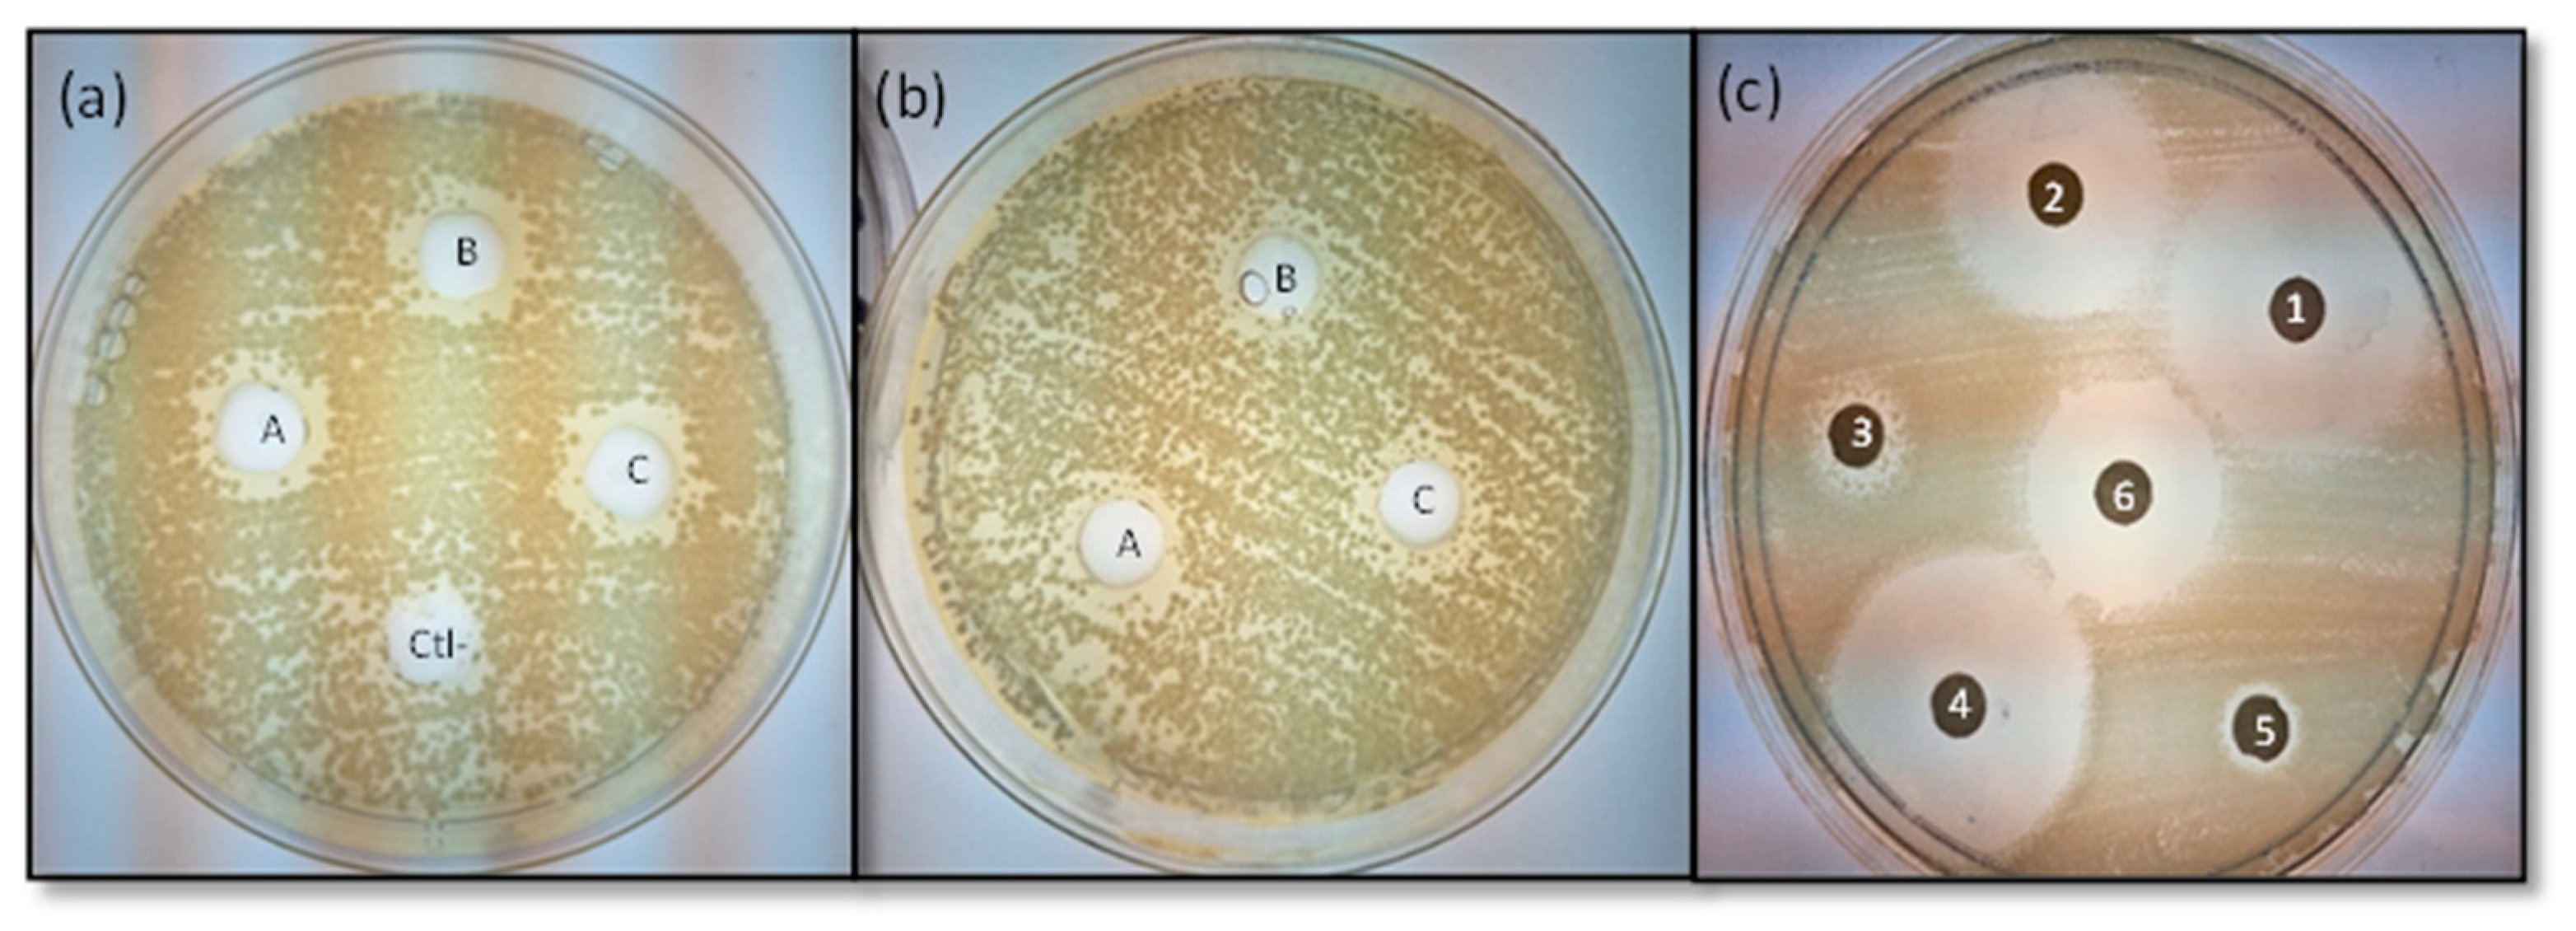
Microbiolres 16 00238 g002

Methanolic Extract of Moringa oleifera Seed Synergizes the Bactericidal Effect of Ampicillin, Cephalexin, and Amoxicillin/Clavulanic Acid Against Multidrug-Resistant Escherichia coli Isolated from Street-Vended Food
Abstract
1. Introduction
2. Materials and Methods
2.1. Food Sampling and E. coli Isolation
2.2. Antibiotic Sensibility Testing
2.3. Secondary Metabolites Extraction of Moringa oleifera Seeds
2.4. Phytochemical Analysis
2.5. Minimum Inhibitory Concentration (MIC), Minimum Bactericidal Concentration (MBC), Tolerance Level, and Antimicrobial Activity
2.6. Effect of the Combination of the Moringa oleifera Seed Extract with Antibiotics
2.7. Statistical Analysis
3. Results
3.1. E. coli Sampling
3.2. Antibiotic Susceptibility
3.3. Secondary Metabolites Extraction and Phytochemical Analysis
3.4. Minimum Inhibitory Concentration, Minimum Bactericidal Concentration and Tolerance Level
3.5. Antimicrobial Activity of the M. oleifera Seed Extracts
3.6. Effect of Antibiotic Interaction with M. oleifera Seed Extract
4. Discussion
5. Conclusions
Supplementary Materials
Author Contributions
Funding
Institutional Review Board Statement
Informed Consent Statement
Data Availability Statement
Acknowledgments
Conflicts of Interest
References
- Arsene, M.M.J.; Viktorovna, P.I.; Davares, A.K.L.; Parfait, K.; Andreevna, S.L.; Mouafo, H.T.; Rehailia, M.; Vyacheslavovna, Y.N.; Pavlovna, S.I.; Manga, I.A.M.; et al. Antimicrobial and Antibiotic-Resistance Reversal Activity of Some Medicinal Plants from Cameroon against Selected Resistant and Non-Resistant Uropathogenic Bacteria. Front. Biosci. Elite 2022, 14, 25. [Google Scholar] [CrossRef] [PubMed]
- Arsene, M.M.J.; Jorelle, A.B.J.; Sarra, S.; Viktorovna, P.I.; Davares, A.K.L.; Ingrid, N.K.C.; Steve, A.A.F.; Andreevna, S.L.; Vyacheslavovna, Y.N.; Carime, B.Z. Short Review on the Potential Alternatives to Antibiotics in the Era of Antibiotic Resistance. J. Appl. Pharm. Sci. 2022, 12, 029–040. [Google Scholar] [CrossRef]
- World Health Organization. Available online: https://www.who.int/news-room/fact-sheets/detail/antimicrobial-resistance (accessed on 2 April 2024).
- Naghavi, M.; Vollset, S.E.; Ikuta, K.S.; Swetschinski, L.R.; Gray, A.P.; Wool, E.E.; Robles Aguilar, G.; Mestrovic, T.; Smith, G.; Han, C.; et al. Global Burden of Bacterial Antimicrobial Resistance 1990–2021: A Systematic Analysis with Forecasts to 2050. Lancet 2024, 404, 1199–1226. [Google Scholar] [CrossRef] [PubMed]
- Svarch, A.E.; Jackeline, M.; Rosales, L.; Contreras, A.V.; Lugo, H.S.; Esmeralda, L.; Vázquez, R.; Sandoval, R.C. Actions to Combat Antimicrobial Resistance in Mexico: A Perspective from COFEPRIS. Rev. Mex. Politica Exter. 2024, 129, 73–86. [Google Scholar]
- Arsene, M.M.J.; Viktorovna, P.I.; Davares, A.K.L.; Esther, N.; Nikolaevich, S.A. Urinary Tract Infections: Virulence Factors, Resistance to Antibiotics, and Management of Uropathogenic Bacteria with Medicinal Plants—A Review. J. Appl. Pharm. Sci. 2021, 11, 1–12. [Google Scholar] [CrossRef]
- Estrada-Garcia, T.; Lopez-Saucedo, C.; Thompson-Bonilla, R.; Abonce, M.; Lopez-Hernandez, D.; Santos, J.I.; Rosado, J.L.; DuPont, H.L.; Long, K.Z. Association of Diarrheagenic Escherichia coli Pathotypes with Infection and Diarrhea among Mexican Children and Association of Atypical Enteropathogenic E. coli with Acute Diarrhea. J. Clin. Microbiol. 2009, 47, 93–98. [Google Scholar] [CrossRef]
- Canizalez-Roman, A.; Gonzalez-Nuñez, E.; Vidal, J.E.; Flores-Villaseñor, H.; León-Sicairos, N. Prevalence and Antibiotic Resistance Profiles of Diarrheagenic Escherichia coli Strains Isolated from Food Items in Northwestern Mexico. Int. J. Food Microbiol. 2013, 164, 36–45. [Google Scholar] [CrossRef]
- Dominguez-Gonzalez, K.G.; Aguilar-Chairez, S.; Cerna-Cortes, J.; Soria-Herrera, R.J.; Cerna-Cortes, J.F. Microbiological Quality and Presence of Foodborne Pathogens in Fresh-Squeezed Orange Juice Samples Purchased from Street Vendors and Hygienic Practices in Morelia, Mexico. Food Sci. Technol. 2022, 42, e10222. [Google Scholar] [CrossRef]
- Cerna-Cortes, J.F.; Gómez-Aldapa, C.A.; Rangel-Vargas, E.; Ramírez-Cruz, E.; Castro-Rosas, J. Presence of Indicator Bacteria, Salmonella and Diarrheagenic Escherichia coli Pathotypes on Mung Bean Sprouts from Public Markets in Pachuca, Mexico. Food Control 2013, 31, 280–283. [Google Scholar] [CrossRef]
- Cerna-Cortes, J.F.; Gómez-Aldapa, C.A.; Rangel-Vargas, E.; Torres-Vitela, M.d.R.; Villarruel-López, A.; Castro-Rosas, J. Presence of Some Indicator Bacteria and Diarrheagenic E. Coli Pathotypes on Jalapeño and Serrano Peppers from Popular Markets in Pachuca City, Mexico. Food Microbiol. 2012, 32, 444–447. [Google Scholar] [CrossRef]
- Mora-Coto, D.; Moreno-Vélez, P.; Luna-Muñoz, J.; Moreno-Campuzano, S.; Ontiveros-Torres, M.A. Intestinal and Extraintestinal Pathotypes of Escherichia coli Are Prevalent in Food Prepared and Marketed on the Streets from the Central Zone of Mexico and Exhibit a Differential Phenotype of Resistance Against Antibiotics. Antibiotics 2025, 14, 406. [Google Scholar] [CrossRef]
- Rojas-Larios, F.; Martínez-Guerra, B.A.; López-Jácome, L.E.; Bolado-Martínez, E.; Vázquez-Larios, M.d.R.; Velázquez-Acosta, M.d.C.; Romero-Romero, D.; Mireles-Dávalos, C.D.; Quintana-Ponce, S.; Feliciano-Guzmán, J.M.; et al. Active Surveillance of Antimicrobial Resistance and Carbapenemase-Encoding Genes According to Sites of Care and Age Groups in Mexico: Results from the INVIFAR Network. Pathogens 2023, 12, 1144. [Google Scholar] [CrossRef]
- Murray, C.J.; Ikuta, K.S.; Sharara, F.; Swetschinski, L.; Robles Aguilar, G.; Gray, A.; Han, C.; Bisignano, C.; Rao, P.; Wool, E.; et al. Global Burden of Bacterial Antimicrobial Resistance in 2019: A Systematic Analysis. Lancet 2022, 399, 629–655. [Google Scholar] [CrossRef] [PubMed]
- Déciga-Campos, M.; Ventura-Martínez, R.; González-Trujano, M.E.; Silveira, D. Editorial: Pharmacological Interaction between Drugs and Medicinal Plants. Front. Pharmacol. 2022, 13, 1081090. [Google Scholar] [CrossRef]
- Prashith Kekuda, T.R.; Mallikarjun, N.; Swathi, D.; Nayana, K.V.; Aiyar, M.B.; Rohini, T.R. Antibacterial and Antifungal Efficacy of Steam Distillate of Moringa oleifera Lam. J. Pharm. Sci. Res. 2010, 2, 34–37. [Google Scholar]
- Anzano, A.; Ammar, M.; Papaianni, M.; Grauso, L.; Sabbah, M.; Capparelli, R.; Lanzotti, V. Moringa oleifera Lam.: A Phytochemical and Pharmacological Overview. Horticulturae 2021, 7, 409. [Google Scholar] [CrossRef]
- Vergara-Jimenez, M.; Almatrafi, M.M.; Fernandez, M.L. Bioactive Components in Moringa oleifera Leaves Protect against Chronic Disease. Antioxidants 2017, 6, 91. [Google Scholar] [CrossRef] [PubMed]
- Araújo, L.C.C.; Aguiar, J.S.; Napoleão, T.H.; Mota, F.V.B.; Barros, A.L.S.; Moura, M.C.; Coriolano, M.C.; Coelho, L.C.B.B.; Silva, T.G.; Paiva, P.M.G. Evaluation of Cytotoxic and Anti-Inflammatory Activities of Extracts and Lectins from Moringa oleifera Seeds. PLoS ONE 2013, 8, e81973. [Google Scholar] [CrossRef]
- Wolff, K.; Jaja-Chimedza, A.; Kim, Y.; Waterman, C.; Poulev, A.; Raskin, I.; Ribnicky, D. Moringa Isothiocyanate-1 Is Bioaccessible and Bioavailable as a Stable Unmodified Compound. Phytochem. Lett. 2020, 38, 33–38. [Google Scholar] [CrossRef]
- Famurewa, A.C.; Asogwa, N.T.; Aja, P.M.; Akunna, G.G.; Awoke, J.N.; Ekeleme-Egedigwe, C.A.; Maduagwuna, E.K.; Folawiyo, A.M.; Besong, E.E.; Ekpono, E.U.; et al. Moringa oleifera Seed Oil Modulates Redox Imbalance and INOS/NF-ĸB/Caspase-3 Signaling Pathway to Exert Antioxidant, Anti-Inflammatory and Antiapoptotic Mechanisms against Anticancer Drug 5-Fluorouracil-Induced Nephrotoxicity in Rats. S. Afr. J. Bot. 2019, 127, 96–103. [Google Scholar] [CrossRef]
- Suphachai, C. Antioxidant and Anticancer Activities of Moringa oleifera Leaves. J. Med. Plants Res. 2014, 8, 318–325. [Google Scholar] [CrossRef]
- Liao, P.C.; Lai, M.H.; Hsu, K.P.; Kuo, Y.H.; Chen, J.; Tsai, M.C.; Li, C.X.; Yin, X.J.; Jeyashoke, N.; Chao, L.K.P. Identification of β-Sitosterol as in Vitro Anti-Inflammatory Constituent in Moringa oleifera. J. Agric. Food Chem. 2018, 66, 10748–10759. [Google Scholar] [CrossRef]
- Govardhan Singh, R.S.; Negi, P.S.; Radha, C. Phenolic Composition, Antioxidant and Antimicrobial Activities of Free and Bound Phenolic Extracts of Moringa oleifera Seed Flour. J. Funct. Foods 2013, 5, 1883–1891. [Google Scholar] [CrossRef]
- Akinyeye, A.J.; Solanke, E.O.; Adebiyi, I.O. Phytochemical and Antimicrobial Evaluation of Leaf and Seed of Moringa olifera Extracts. Int. J. Res. Med. Health Sci. 2014, 4, 1–10. [Google Scholar]
- Dinesha, B.L.; Nidoni, U.; Ramachandra, C.T.; Naik, N.; Sankalpa, K.B. Effect of Extraction Methods on Physicochemical, Nutritional, Antinutritional, Antioxidant and Antimicrobial Activity of Moringa (Moringa oleifera Lam.) Seed Kernel Oil. J. Appl. Nat. Sci. 2018, 10, 287–295. [Google Scholar] [CrossRef]
- Emmanuel, S.A.; Abubakar, S. Phytochemical and Antimicrobial Studies of Methanol, Ethyl Acetate, and Aqueous Extracts of Moringa oleifera Seeds. Ame. J. Eth. 2014, 1, 346–354. [Google Scholar]
- Fowoyo, P.; Olalekan Oladoja, E. Phytochemical Screening, Nutritional Composition and Antimicrobial Activity of Moringa oleifera Seed and Leaf Extract against Selected Gastrointestinal Pathogens. Artic. IOSR J. Pharm. Biol. Sci. 2015, 10, 116–124. [Google Scholar]
- Forsman, L.D.; Giske, C.G.; Bruchfeld, J.; Schön, T.; Juréen, P.; Ängeby, K. Meropenem-Clavulanic Acid Has High in Vitro Activity against Multidrug-Resistant Mycobacterium Tuberculosis. Antimicrob. Agents Chemother. 2015, 59, 3630–3632. [Google Scholar] [CrossRef]
- Alsahli, A.A.; Al Sahli, A.A.; Abdulkhair, W.M. Inhibition of Beta-Lactamase Enzyme of Pseudomonas Aeruginosa by Clavulanic Acid of Rumex vesicarius L. Afr. J. Agric. Res. 2011, 6, 2908–2915. [Google Scholar]
- Ilanko, P.; McDonnell, P.A.; van Vuuren, S.; Cock, I.E. Interactive Antibacterial Profile of Moringa oleifera Lam. Extracts and Conventional Antibiotics against Bacterial Triggers of Some Autoimmune Inflammatory Diseases. S. Afr. J. Bot. 2019, 124, 420–435. [Google Scholar] [CrossRef]
- CLSI M02; Performance Standards for Antimicrobial Disk Susceptibility Tests. 13th ed. Clinical Laboratory Standards Institute: Wayne, PA, USA, 2018.
- Vineetha, N.; Sridhar, D.; Vignesh, R.A. Preparation, Standardization of Antibiotic Discs and Study of Resistance Pattern for First-Line Antibiotics in Isolates from Clinical Samples. Int. J. Appl. Res. 2015, 1, 624–631. [Google Scholar]
- CLSI M2-A9; Performance Standards for Antimicrobial Disk Susceptibility Tests; Approved Standard—9th ed. Clinical Laboratory Standards Institute: Wayne, PA, USA, 2006; Volume 26.
- Abubakar, I.; Usman, A. Phytochemical and Antibacterial Investigations of Moringa (Moringa oleifera) Leaf Extract on Selected Bacterial Pathogens. J. Microbiol. Antimicrob. 2016, 8, 28–33. [Google Scholar] [CrossRef]
- Jones, W.P.; Kinghorn, A.D. Natural Products Isolation, 2nd ed.; Humana Press: Totowa, NJ, USA, 2012; pp. 323–346. [Google Scholar]
- Doughari, J.H.; Pukuma, M.S.; De, N. Antibacterial Effects of Balanites Aegyptiaca L. Drel. and Moringa oleifera Lam. on Salmonella Typhi. Afr. J. Biotechnol. 2007, 6, 2212–2215. [Google Scholar] [CrossRef]
- Savithramma, N.; Linga Rao, M.; Ankanna, S. Screening of Medicinal Plants for Secondary Metabolites. Int. Res. Pharm. Sci. 2011, 2, 643–647. [Google Scholar]
- Saquib, S.A.; AlQahtani, N.A.; Ahmad, I.; Kader, M.A.; Al Shahrani, S.S.; Asiri, E.A. Evaluation and Comparison of Antibacterial Efficacy of Herbal Extracts in Combination with Antibiotics on Periodontal Pathobionts: An in Vitro Microbiological Study. Antibiotics 2019, 8, 89. [Google Scholar] [CrossRef]
- Daly, S.M.; Sturge, C.R.; Greenberg, D.E. Inhibition of Bacterial Growth by Peptide-Conjugated Morpholino Oligomers. Meth. Mol. Biol. 2017, 1565, 115–122. [Google Scholar] [CrossRef]
- Balouiri, M.; Sadiki, M.; Ibnsouda, S.K. Methods for in Vitro Evaluating Antimicrobial Activity: A Review. J. Pharm. Anal. 2016, 6, 71–79. [Google Scholar] [CrossRef]
- Faisal Madhloom, A.; Bashir Hashim Al-Taweel, F.; Sha, A.M.; Raad Abdulbaqi, H. Antimicrobial Effect of Moringa oleifera L. and Red Pomegranate against Clinically Isolated Porphyromonas Gingivalis: In Vitro Study. Arch. Razi Inst. 2022, 77, 1405–1419. [Google Scholar] [CrossRef] [PubMed]
- Gómez-Aldapa, C.A.; Del Refugio Torres-Vitela, M.; Acevedo-Sandoval, O.A.; Rangel-Vargas, E.; Villarruel-López, A.; Castro-Rosas, J. Presence of Shiga Toxin-Producing Escherichia coli, Enteroinvasive E. coli, Enteropathogenic E. coli, and Enterotoxigenic E. coli on Tomatoes from Public Markets in Mexico. J. Food Prot. 2013, 76, 1621–1625. [Google Scholar] [CrossRef] [PubMed]
- de la Rosa-Hernandez, M.C.; Cadena-Ramírez, A.; Téllez-Jurado, A.; Gómez-Aldapa, C.A.; Rangel-Vargas, E.; Chávez-Urbiola, E.A.; Castro-Rosas, J. Presence of Multidrug-Resistant Shiga Toxin–Producing Escherichia coli, Enteropathogenic Escherichia coli, and Enterotoxigenic Escherichia coli on Fresh Cheeses from Local Retail Markets in Mexico. J. Food Prot. 2018, 81, 1748–1754. [Google Scholar] [CrossRef]
- Ríos-Muñiz, D.; Cerna-Cortés, J.F.; Morán-García, N.; Meza-Segura, M.; Estrada-García, T. Escherichia coli Enterotoxigénica y Enteroagregativa: Prevalencia, Patogénesis y Modelos Múridos. Gac. Med. Mex. 2019, 155, 410–416. [Google Scholar] [CrossRef] [PubMed]
- Khare, T.; Anand, U.; Dey, A.; Assaraf, Y.G.; Chen, Z.S.; Liu, Z.; Kumar, V. Exploring Phytochemicals for Combating Antibiotic Resistance in Microbial Pathogens. Front. Pharmcol 2021, 12, 720726. [Google Scholar] [CrossRef]
- Vankwani, S.; Ansari, A.; Azhar, A.; Galani, S. Synergistic Evaluation of Moringa oleifera Extract and SS-Lactam Antibiotic to Restore the Susceptibility of Methicillin-Resistant Staphylococcus aureus. Mol. Biol. Rep. 2022, 49, 421–432. [Google Scholar] [CrossRef]
- Enan, G.; Al-Mohammadi, A.R.; Mahgoub, S.; Abdel-Shafi, S.; Askar, E.; Ghaly, M.F.; Taha, M.A.; El-Gazzar, N. Inhibition of Staphylococcus aureus LC 554891 by Moringa oleifera Seed Extract Either Singly or in Combination with Antibiotics. Molecules 2020, 25, 4583. [Google Scholar] [CrossRef]
- El-Fakharany, E.M.; Elsharkawy, W.B.; El-Maradny, Y.A.; El-Gendi, H. Moringa oleifera Seed Methanol Extract with Consolidated Antimicrobial, Antioxidant, Anti-Inflammatory, and Anticancer Activities. J. Food Sci. 2024, 89, 5130–5149. [Google Scholar] [CrossRef]
- Garga, M.A.; Manga, S.B.; Rabah, A.B.; Tahir, H.; Abdullahi, M.; Ahmad, M.; Abdullahi, H.A.; Bako, I.; Abdurrahman, S.A.; Mukhtar, U.F. Antibacterial Activity and Phytochemical Screening of Moringa oleifera Lam. Leaves and Seeds Extract on Staphylococcus aureus. Int. J. Res. 2019, 7, 276–284. [Google Scholar] [CrossRef]
- Chaachouay, N. Synergy, Additive Effects, and Antagonism of Drugs with Plant Bioactive Compounds. Drugs Drug Candidates 2025, 4, 4. [Google Scholar] [CrossRef]
- Narendrakumar, L.; Chakraborty, M.; Kumari, S.; Paul, D.; Das, B. β-Lactam Potentiators to Re-Sensitize Resistant Pathogens: Discovery, Development, Clinical Use and the Way Forward. Front. Microbiol. 2022, 13, 1092556. [Google Scholar] [CrossRef]
- Yamasaki, S.; Zwama, M.; Yoneda, T.; Hayashi-Nishino, M.; Nishino, K. Drug Resistance and Physiological Roles of RND Multidrug Efflux Pumps in Salmonella enterica, Escherichia coli and Pseudomonas aeruginosa. Microbiol. (UK) Microbiol. Soc. 2023, 169, 001322. [Google Scholar] [CrossRef] [PubMed]
- Maurya, A.; Dwivedi, G.R.; Darokar, M.P.; Srivastava, S.K. Antibacterial and Synergy of Clavine Alkaloid Lysergol and Its Derivatives Against Nalidixic Acid-Resistant Escherichia coli. Chem. Biol. Drug Des. 2013, 81, 484–490. [Google Scholar] [CrossRef]
- Moulick, S.; Bera, R.; Roy, D.N. Bactericidal Action of Ginger (Zingiber officinale Roscoe) Extract against Escherichia coli through Synergistic Modulation of the AcrAB-TolC Efflux Pump and Inhibition of Peptidoglycan Synthesis: In Vitro and in Silico Approaches. Microb. Pathog. 2025, 204, 107624. [Google Scholar] [CrossRef] [PubMed]
- Dzotam, J.K.; Touani, F.K.; Kuete, V. Antibacterial and Antibiotic-Modifying Activities of Three Food Plants (Xanthosoma mafaffa Lam., Moringa oleifera (L.) Schott and Passiflora edulis Sims) against Multidrug-Resistant (MDR) Gram-Negative Bacteria. BMC Complement. Altern. Med. 2016, 16, 9. [Google Scholar] [CrossRef]
- Spencer, A.C.; Panda, S.S. DNA Gyrase as a Target for Quinolones. Biomedicines 2023, 11, 371. [Google Scholar] [CrossRef]
- Marshall, A.J.H.; Piddock, L.J.V. Interaction of Divalent Cations, Quinolones and Bacteria. J. Antimicrob. Chem. 1994, 34, 465–483. [Google Scholar] [CrossRef] [PubMed]
- Liang, L.; Wang, C.; Li, S.; Chu, X.; Sun, K. Nutritional Compositions of Indian Moringa oleifera Seed and Antioxidant Activity of Its Polypeptides. Food Sci. Nutr. 2019, 7, 1754–1760. [Google Scholar] [CrossRef] [PubMed]

| Food Type | Description | Year of Sampling | Sample |
|---|---|---|---|
| Group 1 | Sauces made from vegetables with or without heating procedures | 2021 | G1-21 |
| 2022 | G1-22 | ||
| 2023 | G1-23 | ||
| Group 2 | Raw vegetables | 2021 | G2-21 |
| 2023 | G2-23 | ||
| Group 3 | Whole fruits, shakes, and juices | 2021 | G3-21 |
| 2022 | G3-22 | ||
| 2023 | G3-23 | ||
| Group 4 | Cooked meat in different presentations and tortillas, bread, and other food made with flour that had undergone heating procedures | 2021 | G4-21 |
| 2022 | G4-22 | ||
| 2023 | G4-23 |
| Secondary Metabolites | Characteristics | Result |
|---|---|---|
| Alkaloids | Lighter color with precipitates | Positive |
| Phenolic compounds | Dark green color | Positive |
| Flavonoids | Yellow color | Positive |
| Tannins | Creamy precipitate | Positive |
| Anthocyanins | No change in the color | Negative |
| Sample | MIC (mg/mL) | MBC (mg/mL) | Tolerance Level (MBC/MIC) | IZE (mm) |
|---|---|---|---|---|
| G1-21 | 62 | 125 | 2.02 | 7.53 ± 0.05 |
| G2-21 | 31.3 | 62 | 1.98 | 11.33 ± 0.12 |
| G3-21 | 62 | 125 | 2.02 | 9.53 ± 0.05 |
| G4-21 | 31.3 | 62 | 1.98 | 6.67 ± 0.06 |
| G1-22 | 62 | 125 | 2.02 | 6.33 ± 0.06 |
| G3-22 | 31.3 | 62 | 1.98 | 8.33 ± 0.06 |
| G4-22 | 62 | 125 | 2.02 | 8.33 ± 0.06 |
| G1-23 | 125 | 250 | 2.00 | 9.23 ± 0.02 |
| G2-23 | 31.3 | 62 | 1.98 | 8.80 ± 0.01 |
| G3-23 | 31.3 | 62 | 1.98 | 8.97 ± 0.01 |
| G4-23 | 62 | 125 | 2.02 | 8.57 ± 0.04 |
Disclaimer/Publisher’s Note: The statements, opinions and data contained in all publications are solely those of the individual author(s) and contributor(s) and not of MDPI and/or the editor(s). MDPI and/or the editor(s) disclaim responsibility for any injury to people or property resulting from any ideas, methods, instructions or products referred to in the content. |
© 2025 by the authors. Licensee MDPI, Basel, Switzerland. This article is an open access article distributed under the terms and conditions of the Creative Commons Attribution (CC BY) license (https://creativecommons.org/licenses/by/4.0/).
Share and Cite
Mora-Coto, D.; Moreno-Vélez, P.R.; Luna-Muñoz, J.; Jarero-Basulto, J.J.; Pérez-Galicia, A.; Moreno-Campuzano, S.; Ontiveros-Torres, M.A. Methanolic Extract of Moringa oleifera Seed Synergizes the Bactericidal Effect of Ampicillin, Cephalexin, and Amoxicillin/Clavulanic Acid Against Multidrug-Resistant Escherichia coli Isolated from Street-Vended Food. Microbiol. Res. 2025, 16, 238. https://doi.org/10.3390/microbiolres16110238
Mora-Coto D, Moreno-Vélez PR, Luna-Muñoz J, Jarero-Basulto JJ, Pérez-Galicia A, Moreno-Campuzano S, Ontiveros-Torres MA. Methanolic Extract of Moringa oleifera Seed Synergizes the Bactericidal Effect of Ampicillin, Cephalexin, and Amoxicillin/Clavulanic Acid Against Multidrug-Resistant Escherichia coli Isolated from Street-Vended Food. Microbiology Research. 2025; 16(11):238. https://doi.org/10.3390/microbiolres16110238
Chicago/Turabian StyleMora-Coto, Daniela, Pedro R. Moreno-Vélez, José Luna-Muñoz, José Jaime Jarero-Basulto, Anahi Pérez-Galicia, Samadhi Moreno-Campuzano, and Miguel Angel Ontiveros-Torres. 2025. "Methanolic Extract of Moringa oleifera Seed Synergizes the Bactericidal Effect of Ampicillin, Cephalexin, and Amoxicillin/Clavulanic Acid Against Multidrug-Resistant Escherichia coli Isolated from Street-Vended Food" Microbiology Research 16, no. 11: 238. https://doi.org/10.3390/microbiolres16110238
APA StyleMora-Coto, D., Moreno-Vélez, P. R., Luna-Muñoz, J., Jarero-Basulto, J. J., Pérez-Galicia, A., Moreno-Campuzano, S., & Ontiveros-Torres, M. A. (2025). Methanolic Extract of Moringa oleifera Seed Synergizes the Bactericidal Effect of Ampicillin, Cephalexin, and Amoxicillin/Clavulanic Acid Against Multidrug-Resistant Escherichia coli Isolated from Street-Vended Food. Microbiology Research, 16(11), 238. https://doi.org/10.3390/microbiolres16110238

